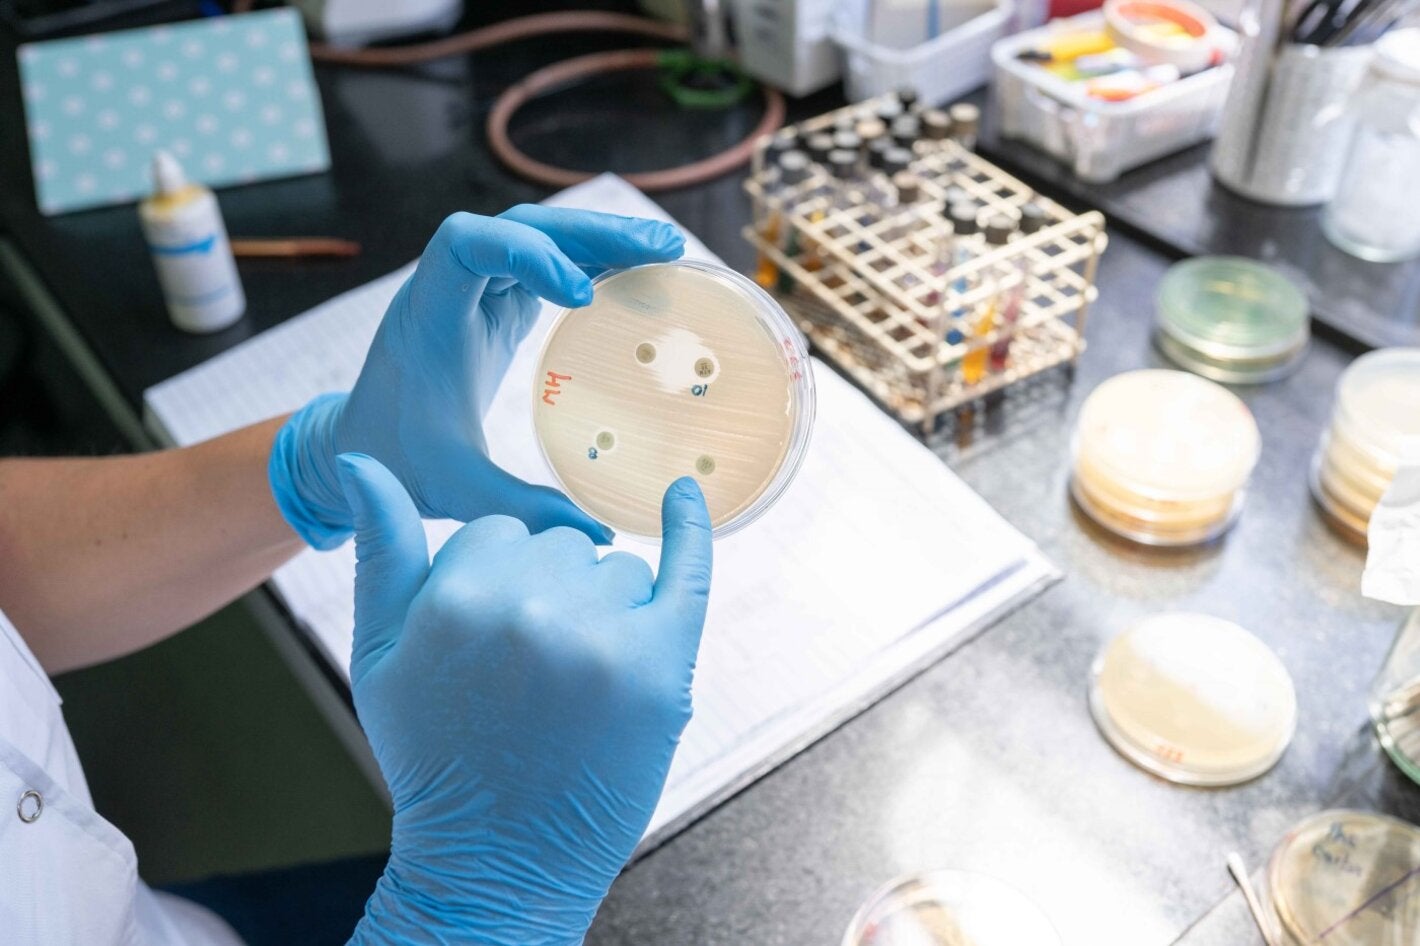

Leadership in Infectious Disease Research and Training in the Region
Malbrán Institute and PAHO work together to build regional capacities in the surveillance of antimicrobial resistance (AMR)
The rise of antimicrobial resistance (AMR) represents one of the greatest threats to human health today. Argentina’s National Institute of Infectious Diseases (INEI ANLIS–Malbrán) and the Pan American Health Organization (PAHO) have been working together for more than two decades to strengthen AMR surveillance and detection capacities at the regional level.
The Malbrán Institute, a public agency under the Ministry of Health of Argentina, has a history of more than 100 years as a national and regional reference institution that conducts research on infectious diseases, working at world-class standards with a multidimensional approach that addresses several strategic areas: reference diagnosis, surveillance, applied research, laboratory quality assurance, training of human resources, and international technical cooperation.
The National Institute of Infectious Diseases (INEI), which is part of Malbrán's structure, is tasked with developing and promoting knowledge about AMR. It also provides support and shares experiences with other countries in the Region to develop and strengthen the technical capacities of laboratories in Argentina and the rest of Latin America and the Caribbean. Since 2020, these activities have expanded throughout the world.
The Institute has a long and technically extensive relationship with PAHO. Malbrán, as it is colloquially known, has been cooperating with PAHO/WHO as a Collaborating Center for more than 40 years, conducting research on diseases such as polio, tuberculosis, Chagas disease, and arbovirus infections. It has also made important contributions in the response to pandemics such as influenza A (H1N1) in 2009 and, most recently, COVID-19.
Sharing knowledge about antimicrobial resistance with Caribbean countries
The Malbrán Institute has been part of the Latin American Network for Antimicrobial Resistance Surveillance (ReLAVRA+) since it was established by PAHO in 1996. Since then, it has contributed to the Network by sharing reliable, timely, and reproducible microbiological data to improve patient care, and has expanded its scope of action to the point of becoming a regional reference laboratory.
Especially innovative has been the Cooperation between Countries for Health Development project implemented between 2019 and 2021 to strengthen the detection and surveillance of AMR in CARICOM Member States. This triangular cooperation was initiated by the Argentine government through the Malbrán Institute and other institutions with CARICOM member countries, and with the technical support of PAHO.
In 2020, INEI ANLIS-Malbrán was designated as a WHO Collaborating Center, after more than two decades of working jointly in AMR surveillance with the countries of Latin America and the Caribbean.
Given its extensive history and scientific knowledge, the Malbrán Institute is an exceptional partner for PAHO that makes extremely valuable contributions to the development and implementation of national AMR containment plans. Malbrán’s ability to transfer knowledge and its commitment to the countries of the Region has made it possible to consolidate quality control programs and strengthen national reference laboratories in the provision of quality data used for decision-making.
For more information
— ANLIS Malbrán
— Antimicrobianos
— En el marco del proyecto de cooperación entre el Gobierno argentino, CARICOM y la OPS se capacitan profesionales del Caribe en resistencia antimicrobiana en el sector animal
— Strengthening national and regional antimicrobial resistance (AMR) detection and surveillance in CARICOM member states 2019-2021 - PAHO/WHO | Pan American Health Organization
— Servicio Antimicrobianos del Instituto Nacional de Enfermedades Infecciosas ANLIS-Malbrán, compromiso con la salud pública en Argentina y el mundo